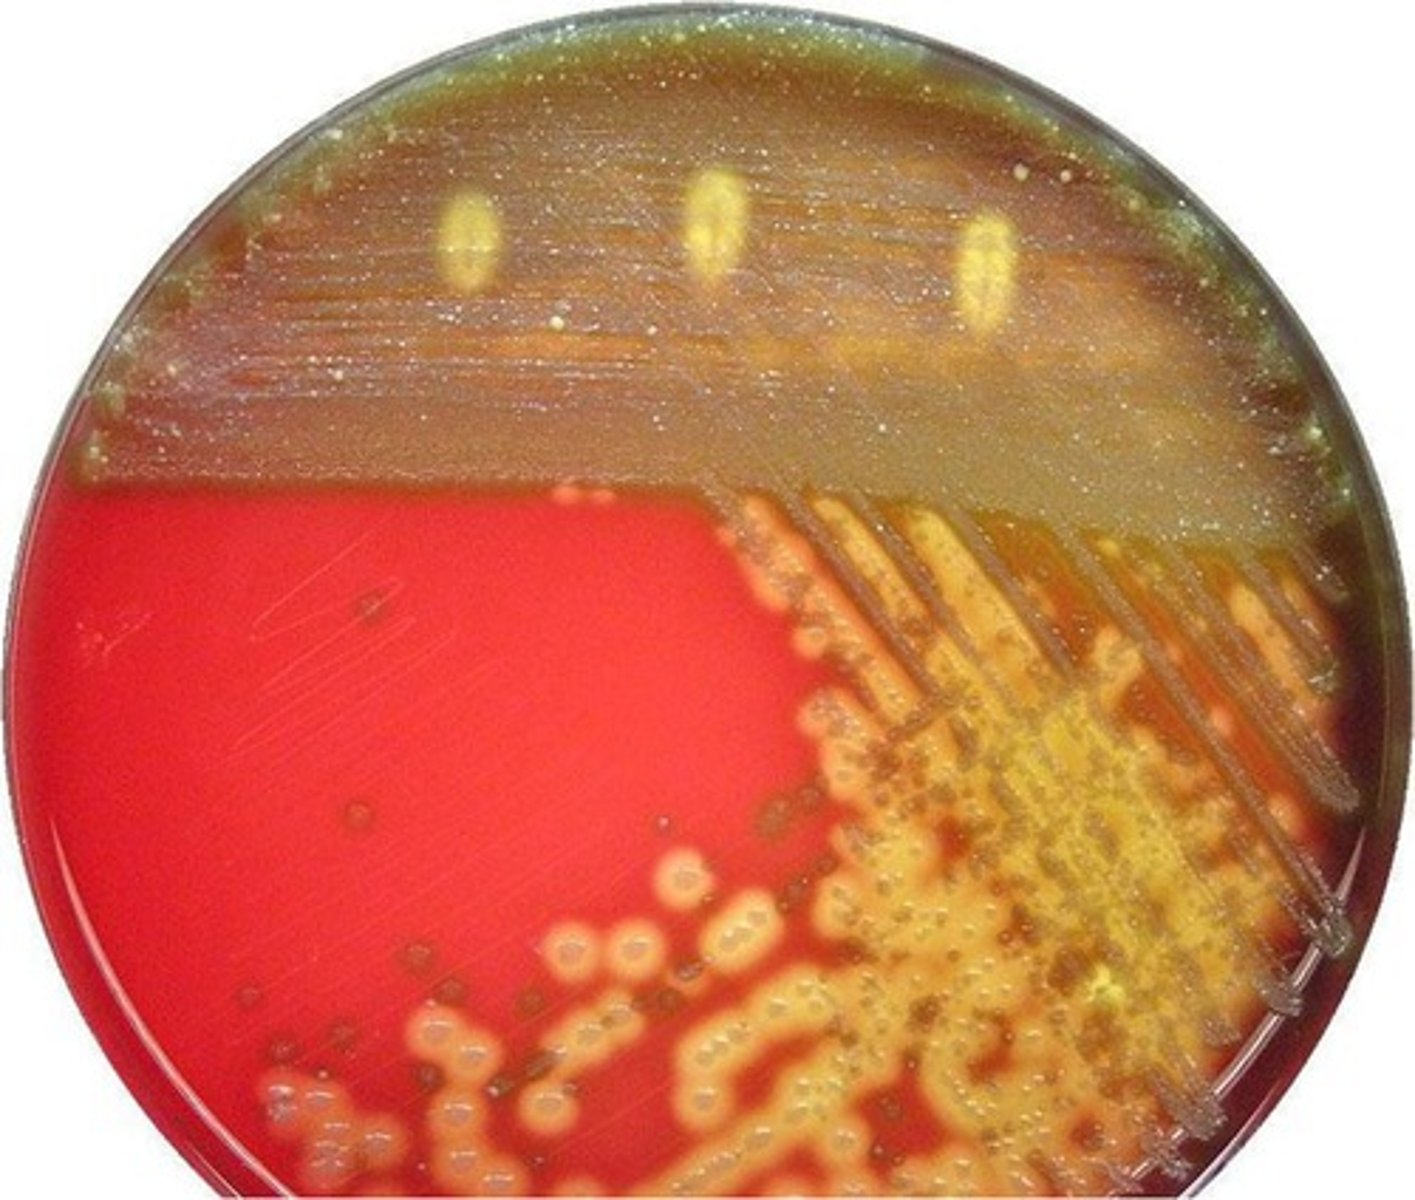
<p>microorganism that is used in clean-up of oil spills</p>

1/25
Looks like no tags are added yet.
Name | Mastery | Learn | Test | Matching | Spaced |
|---|
No study sessions yet.
fossil fuel
coal, oil, natural gas, mainly decomposed plant material, NONRENEWABLE

petroleum
liquid fossil fuel; oil

crude oil
petroleum that has not been processed,
unrefined petroleum

peak oil
moment in time of maximum oil production
oil reserves
oil deposits that can be extracted profitably at current prices using current technology
Conventional Petroleum Reserves
Liquid deposits that contain freely flowing oil or oil that can be pumped out
petrochemicals
chemicals derived from petroleum

natural gas
Fossil fuel consisting of methane that occurs naturally underground

hydraulic fracturing (fracking)
method of removing natural gas from the ground

unconventional oil reserves
recoverable oil reserves whose extractionn is economically and environmentally costly,
oil shale
shale from which oil can be obtained by heating

oil tar sands
crude bitumem, crude mixed in sand that is environmentally harmful to extract

energy security
the supply of useful energy to a society for individual consumption and national security
energy inependence
meeting nations energy needs without importing fuel
fractional distillation
a process of separating petroleum into its components by heating and condensing the components

oil refinery
A factory where crude oil is cleaned and turned into useful oil products

brine
Water saturated with salt.
bioplastic
plastic that is made from renewable biomass sources (cornstarch)

biofuels
renewable fuels derived from biological materials that can be regenerated

renewable energy
energy from a source that is not depleted when used, such as wind or solar power.

hydrocarbons
organic molecules that are composed of only carbon and hydrogen

deep water horizon
The oil well that exploded in the gulf of Mexico in 2010

oil spill
waste usually deposited in the seas and oceans after an accident at sea

oil eating bacteria
microorganism that is used in clean-up of oil spills
skimmer
a device used to remove oil slicks on the surface of the water.
dispersant
a chemical used in oil spill cleanup that thins and dissolves the thick crude